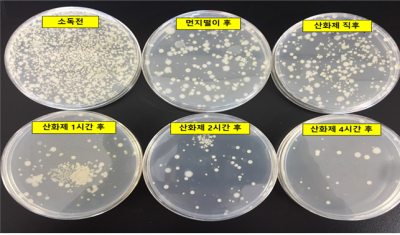

[충청뉴스큐] 농촌진흥청은 가을철 효율적인 가축 질병 차단 방역을 위해 가금 농장에서 반드시 지켜야 하는 소독 요령을 제시했다.
올해 10월 1일부터 내년 2월 28일까지는 농림축산식품부가 관련 단체 등과 협의해 지정한 구제역과 고병원성 조류인플루엔자 특별방역대책 기간이다.
우리나라에서 HPAI가 발생한 것은 2003년부터 지금까지 모두 7차례로, 발생할 때마다 전국으로 확산해 막대한 사회적, 경제적 손실로 이어졌다.
농촌진흥청은 지난해 가금농장의 차량과 발판 소독 효과를 실험한 데 이어, 올해는 겨울철 권장 소독제를 이용해 신발과 손 소독의 세균 억제 효과를 발표했다.
신발을 산화제 계열 소독제 100배 희석액과 강알칼리성 소석회 5배 희석액에 3초 이상 담가둔 결과, 산화제 계열 소독제는 4시간이 지난 뒤부터, 소석회 수용액은 소독 직후 세균 억제 효과가 가장 높았다.
또한, 손은 시중에서 쉽게 구할 수 있는 약산성 차아염소산 제제로 소독했을 때 세균 수가 88% 이상 억제됐다.
따라서, 장화 등 신발은 축사 안에서 작업을 마치고 나올 때 산화제 계열 소독액에 담가 놓고, 작업하러 들어갈 때는 소석회 수용액에 3초 이상 담근 뒤 축사 안으로 들어가도록 한다.
손 소독제는 축사에 진입하기 전 입구 벽면 등 눈에 쉽게 띌 수 있는 곳에 충분한 양을 두고 출입할 때마다 사용하도록 한다.
농촌진흥청 국립축산과학원 가금연구소 박기태 수의연구사는 "신발과 손 소독은 국내 가금 농가 환경에서 반드시 지켜야 하는 원칙이다."라며,"올바른 소독 방법을 습관화해 악성 세균과 바이러스의 유입을 최소화해야 한다."라고 전했다.
가금농장에는 유해 세균과 바이러스가 쉽게 들어오지 못하도록 축사 안팎으로 통하는 곳에 간이 공간을 설치하는 것도 효율적이다.
저작권자 © 충청뉴스큐 무단전재 및 재배포 금지












